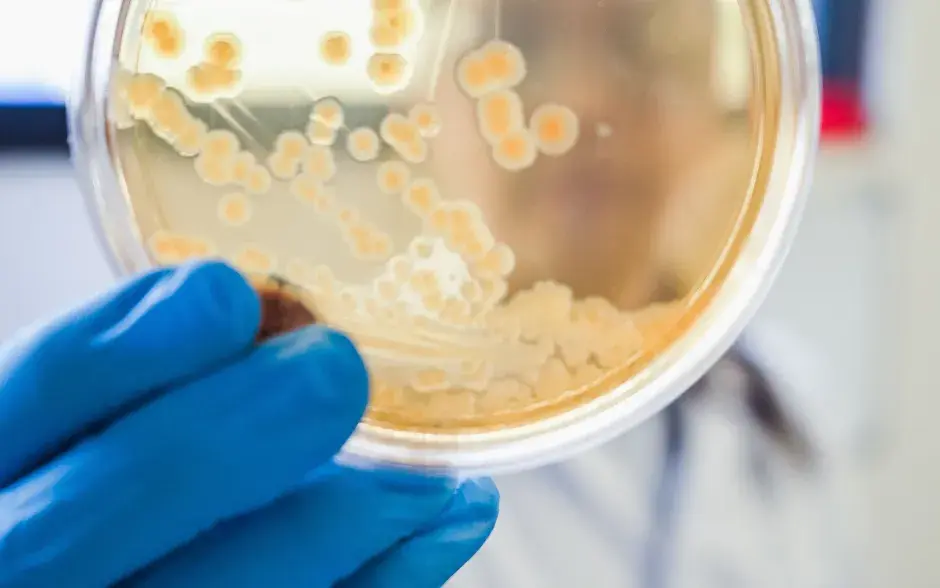
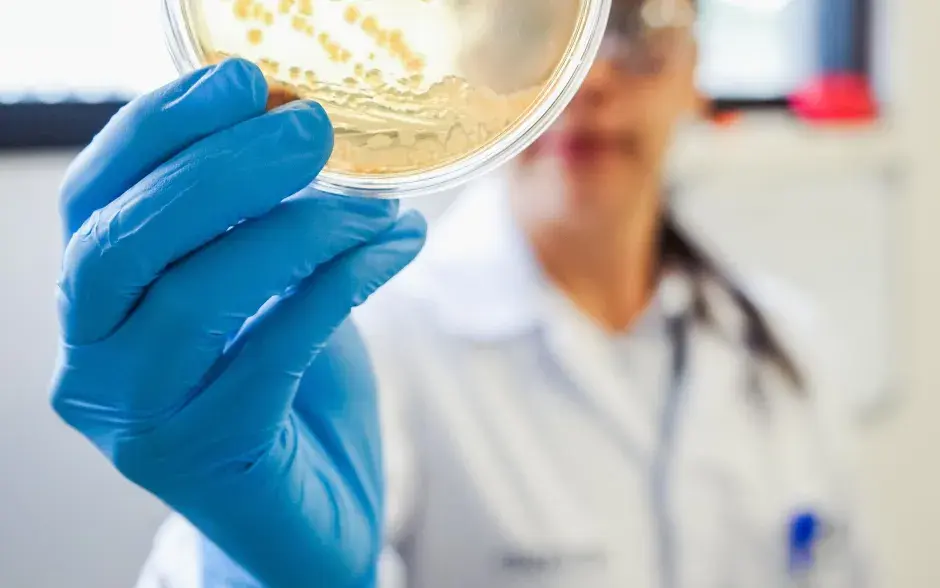
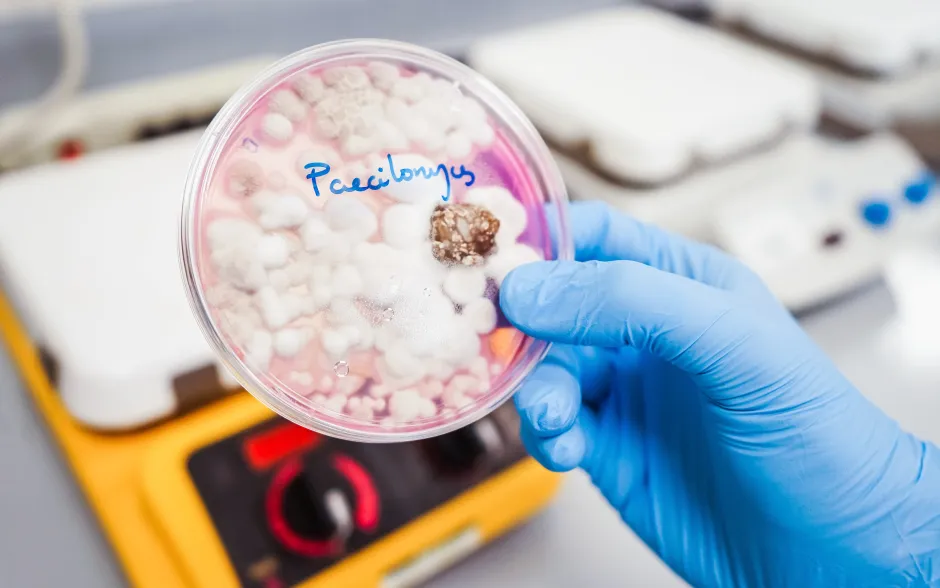
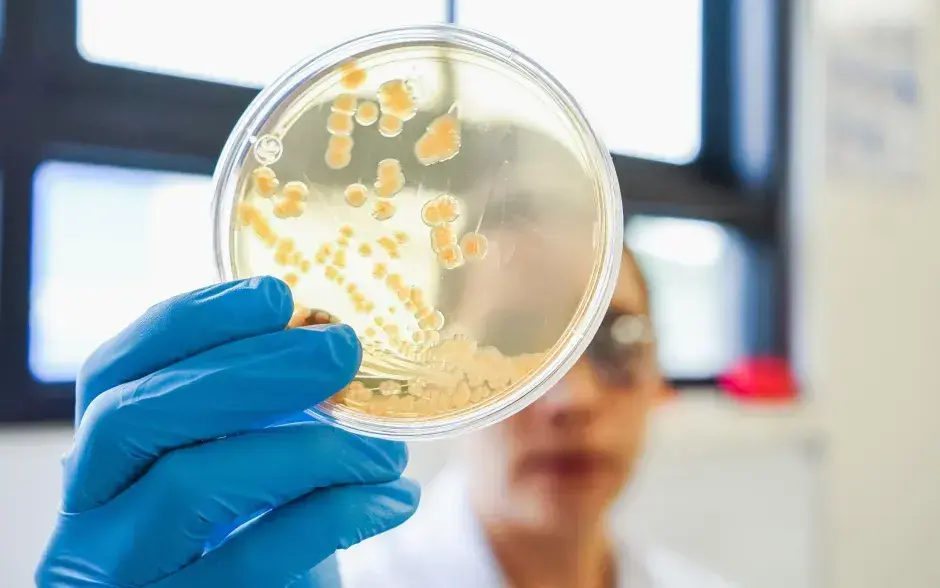
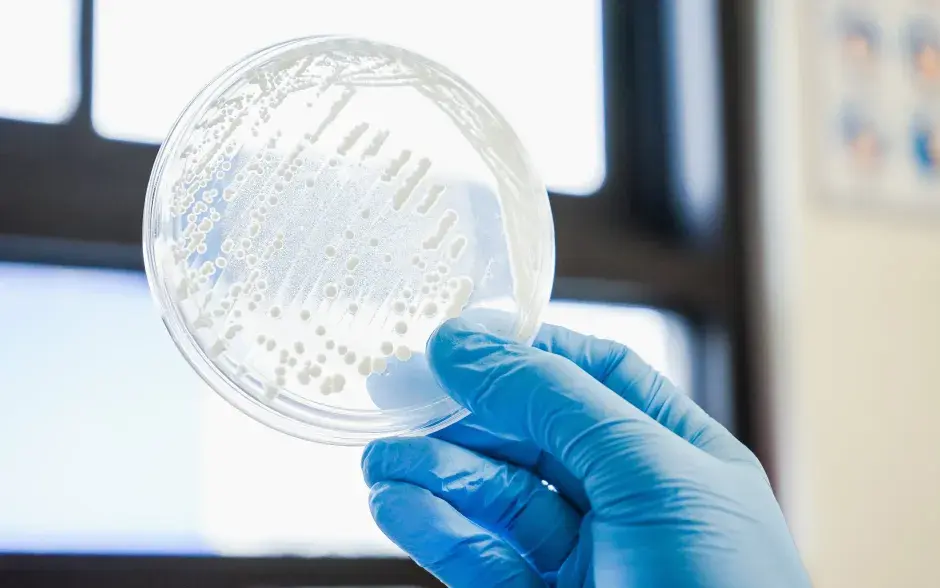

Se ofertan los siguientes ensayos en agua potable, piscina, residual:
- Determinación de coliformes totales, coliformes fecales y Escherichia coli.
- Determinación de Salmonella spp.
- Determinación de Pseudomonas aeruginosa
- Determinación de Enterococcus faecalis
- Recuento heterótrofo en placa.
- Determinación de Legionella pneumophila.
Se ofertan los siguientes ensayos en alimentos, superficies y otras matrices:
- Determinación de coliformes totales, coliformes fecales y Escherichia coli.
- Recuento de hongos filamentosos y levaduras.
- Recuento mesófilo aerobio.
- Recuento de Staphylococcus aureus.
- Presencia de Salmonella spp.
- Presencia de E. coli O157:H7.
- Presencia de Listeria monocytogenes.
- Recuento mesófilo aerobio.
- Recuento de bacterias lácticas.
- Recuento de Vibrio parahaemolyticus.
- Presencia de Campylobacter sp.
- Pruebas de esterilidad
- Prueba de actividad antibacteriana y antifúngica
- Determinación de Clostridium sp.
- Determinación de Aflatoxinas.
- Determinación de antibióticos en leche.
Otros servicios ofertados:
- Muestreo compuesto y puntual de aguas residuales de tipo doméstico e industrial.
- Muestreo de aguas, ríos, piscinas y redes municipales.
- Muestreo de alimentos.
- Muestreo de superficies.